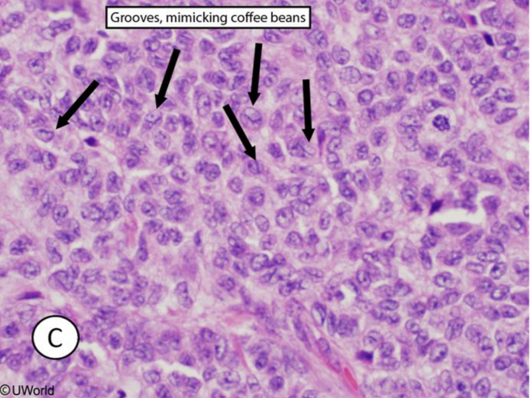
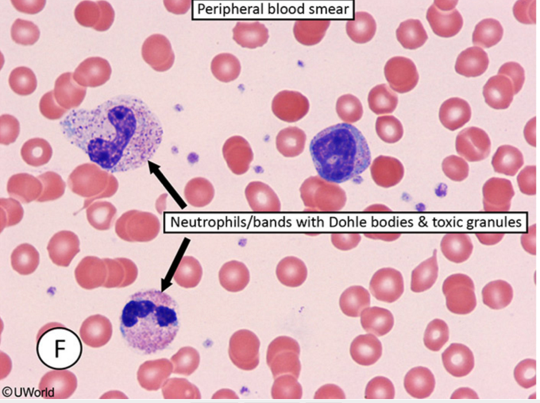
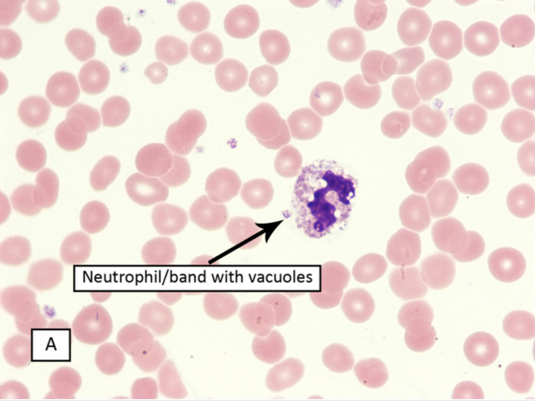
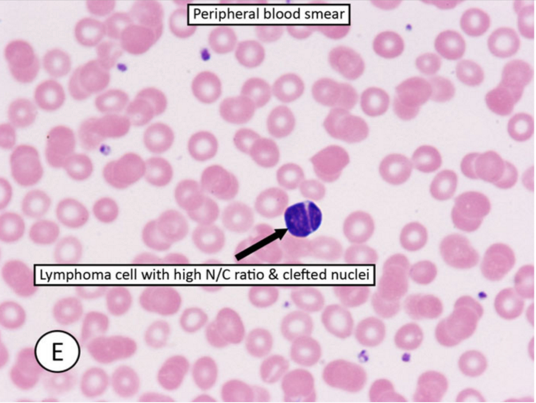
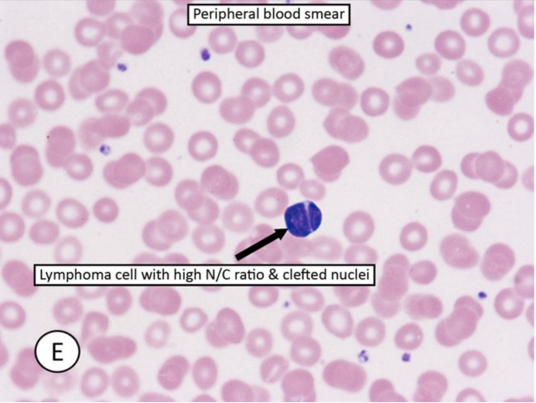

Uworld Notes 3
06/02/2017
CO vs Sickle Cell
The ability of HbS to polymerize helps stabilize the deoxygenated form, causing a right shift of the oxygen-hemoglobin dissociation curve that facilitates oxygen unloading. In contrast, impaired oxygen unloading occurs with carboxyhemoglobin due to an allosteric change that increases the affinity of the remaining 3 oxygen-binding sites, causing left shift.
Ovarian Cancer

Yolk sac tumor:

Granulosa cells:
Teratoma:

Endometriosis:

Psoriasis
The pathogenesis of psoriasis is complex, involving CD4+ and CD8+ T cells, dendritic cells, and surrounding keratinocytes. The interactions among these cells result in the production of TH1- and TH17-type cytokines (including TNF-α, IL-12, IFN-γ, IL-23, and IL-17) and keratinocyte growth factors, leading to keratinocyte proliferation, inflammation, and angiogenesis.
A number of topical and systemic therapies are available for treating psoriasis. Topical vitamin D analogs are frequently used and include calcipotriene (calcipotriol), calcitriol, and tacalcitol. These medications bind to and activate the vitamin D receptor, a nuclear transcription factor that causes inhibition of keratinocyte proliferation and stimulation of keratinocyte differentiation. Treatment with vitamin D analogs has also been shown to inhibit T cell proliferation and other inflammatory mediators.
Photo Aging
_..
Multiple environmental factors, especially exposure to ultraviolet (UV) light, contribute to aging of the skin. UVB wavelengths are predominantly absorbed in the upper dermis and contribute to sunburn and increased risk of malignancy. UVA wavelengths penetrate deeper into skin and cause photoaging. UVA produces reactive oxygen species, which activate multiple inflammatory cell-surface receptors and nuclear transcription factors. This leads to decreased collagen fibril production, along with upregulation of matrix metalloproteinases (including collagenases) that subsequently degrade type I and III collagen and elastin.
Photoaging may be visible by age 30-35. Gradual thinning of the epidermis is seen, with reduction in subcutaneous fat, blood vessels, hair follicles, sweat ducts, and sebaceous glands. Rete ridges at the dermoepidermal junction become flattened. This loss of subcutaneous tissue causes the skin to become atrophic and more vulnerable to damage. In addition, there is increased crosslinking of collagen, with deposition of collagen breakdown products. The atrophic dermis and increased collagen crosslinking, along with desiccation of the stratum corneum, produce the characteristic wrinkling of photoaged skin.
Pacinian
Pacinian corpuscles are rapidly adapting mechanoreceptors located in the subcutaneous tissue of the skin as well as the mesentery, peritoneum, and joint capsules. Ruffini’s end organs are slowly adapting mechanoreceptors that exist in the skin, subcutaneous tissue, and joint capsule. Both help to mediate touch, proprioception, and vibratory sensation and are innervated by myelinated A-beta fibers.
Spindle and Golgi


Alpha motor neuron comes from corticospinal, activates extrafusal fibers. Gamma motor neuron activates intrafusal fiber and keeps spindle activated to keep a constant 1a signal.
The Golgi tendon organs (GTOs) are sensory receptors located at the junction of the muscle and tendon that are innervated by group Ib sensory axons. GTOs are connected in series with the contracting extrafusal skeletal muscle fibers. When a muscle actively contracts against resistance, the increase in tension is transmitted through the tendon activating the GTOs in the process. In contrast, GTOs are relatively insensitive to changes in muscle length because the lengthening that occurs when a muscle is passively stretched takes place primarily in the muscle fibers and not in the tendon.
The Ib sensory axons from the GTOs contact inhibitory interneurons in the spinal cord, which in turn synapse with the α motor neurons that innervate the same muscle. Thus, the Golgi tendon circuit is a negative feedback system that regulates and maintains muscle tension. When a muscle exerts too much force, the GTOs inhibit contraction of the muscle, causing sudden muscle relaxation. This prevents damage to the musculoskeletal system.
In contrast to the in-series arrangement of GTOs, muscle spindles (intrafusal muscle fibers) are connected in parallel with extrafusal fibers. They are innervated by group Ia and group II sensory axons and are sensitive to changes in muscle length. Muscle spindles mediate the stretch reflex (myotatic reflex), which is commonly tested (deep tendon reflexes) during the neurologic examination. When a muscle is stretched, there is monosynaptic reflex activation of the α motor neuron (of the same muscle), causing contraction that resists the stretch.
Ecchymosis
petechiae: < 5mm
purpura: 5 - 1cm
ecchymosis: > 1cm
All are nonblanching
Lactic Acidosis

Aspiration Pneumonia


Smooth ER
In contrast to the RER, the smooth ER (SER) contains enzymes for steroid and phospholipid biosynthesis. All steroid-producing cells (eg, cells in the adrenals, gonads, and liver) contain a well-developed SER.
Shigella Pathogenesis
Shigella cannot bind all intestinal cells. Shigella exhibits specificity for the microfold (M) cells at the base of mucosal villi within a Peyer patch region of the ileal mucosa. M cells sample gut lumen contents and transfer antigens to their basal lamina within endosomes. At the base of the cell, macrophages and lymphocytes ready to mount an immune response await within a special pocket (microfold).
Shigella penetrates the mucous membrane by passing through M cells via endocytosis. It subsequently lyses the endosome, multiplies, and spreads laterally into other epithelial cells. This results in denuding and ulceration of the mucosa and subsequent leakage of blood, inflammatory elements, and mucus into the intestinal lumen. Patients pass frequent stools mixed with blood and mucus. Stools are frequent and loose due to water absorption inhibition.
Endothelial cells form the innermost lining of blood vessels. The Shiga-like toxin of Escherichia coli O157:H7 can cause toxicity to renal endothelial cells, leading to renal insufficiency and uremia.
Dubin Johnson
Grossly, the liver appears black due to impaired excretion of epinephrine metabolites that accumulate within lysosomes.
Syphillis Ddx
syphilis: painless, non-exudative, clean, hard base with indurated margins ("punched out base with rolled edges")
Klebsiella granulomatis: granuloma inguinale, painless ulcer with a beefy red base and irregular borders
Hemophilus ducrevi: chancroid, as a deep, undermined, painful purulent ulcer with soft ragged edges
Recombination
A virologist is researching acyclovir-resistant herpes simplex virus (HSV). Viral DNA analysis reveals a mutation in the thymidine kinase gene, resulting in a mutated enzyme that does not phosphorylate acyclovir to its active form. In an experiment, a resistant HSV type 2 strain containing this mutation is cultured in a cell line, and the cell culture is coinfected with a nonresistant HSV type 1 strain. It is found that some of the newly produced type 1 virions acquire resistance to acyclovir, and subsequent progeny continue to be resistant. Which of the following mechanisms best explains the observed findings?

This scenario describes the exchange of genetic information between 2 virus strains that have nonsegmented, double-stranded DNA genomes. Recombination refers to the exchange of genes between 2 chromosomes via crossing over within homologous regions. The resulting progeny can have recombined genomes with traits from both parent viruses. In this case, the thymidine kinase genes in HSV type 1 and 2 virions are likely to have significant sequence similarity, allowing cross over to occur with relatively high frequency.
Phenotypic Mixing

The acquisition of a new viral surface protein is often all that is necessary for a virus to infect a new type of host cell. In this scenario, avian and human influenza virus particles infect host pig cells; certain progeny avian virus particles obtain some of the surface components (eg, sialic acid receptors) of the human influenza virus, allowing the avian virus to infect human cells. This exchange is an example of phenotypic mixing, which generally occurs when a host cell is coinfected with 2 viral strains and progeny virions contain unchanged parental genome from one strain and nucleocapsid (or envelope) proteins from the other strain. However, because there is no change in the underlying viral genomes (no genetic exchange), subsequent progeny will revert to having only avian influenza type surface proteins and will again be noninfectious to human epithelium.
Emphysema and Hypoxia
Emphysema causes hypoxia by dilating the alveolar air spaces so that there is insufficient contact between the airspaces and deoxygenated blood in the alveolar capillaries.
Actinomyces

sulfur granules
DNA Binding Domain
The protein produced in the bioreactor contains a DNA-binding domain. DNA-binding proteins are a diverse group that include
transcription factors (Myc, CREB)
steroid receptors (cortisol, aldosterone, progesterone)
thyroid hormone receptor
fat-soluble vitamin receptors (vitamin D, retinoic acid)
DNA transcription and replication proteins
Antibody Naming

Bacteria Toxin

Radial Head Subluxation

This patient is experiencing radial head subluxation (nursemaid’s elbow), the most common elbow injury in children. It occurs most frequently between the ages of 1 to 4 years. This injury often results from a sharp pull on the hand while the forearm is pronated and the elbow is extended. The sudden increase in axial traction on the proximal radius causes the annular ligament to tear from its periosteal attachment at the radial neck. It then slips over the head of the radius and slides into the radiohumeral joint, where it becomes trapped. By age 5, the annular ligament becomes thick and strong, decreasing the likelihood that it can be torn or displaced.
Affected children present with the injured arm held close to the body with the elbow extended (or slightly flexed) and the forearm pronated. The child is typically in little distress until attempts are made to move the elbow. Mild tenderness can be elicited on palpation of the subluxed radial head. Reduction can be accomplished by fully supinating the child’s forearm followed by fully flexing the elbow.
Superior to Arcuate Line

Gas Anesthetics

RNA Interference

RNA interference is an important mechanism by which short (20-30 base pair) non-coding RNA sequences induce posttranscriptional gene silencing. Types of silencing RNA include small interfering RNA (siRNA) and microRNA (miRNA). The human genome encodes over 1000 miRNA genes, each one capable of repressing hundreds of target genes. Altered expression of even a few miRNA genes can lead to cellular dysregulation and has been implicated in the development of many diseases, including hematologic and solid malignancies. In addition, synthetic siRNA sequences can be introduced into cells to silence specific pathogenic genes (eg, c-Myc oncogene) and are being explored as possible therapeutic agents.
After being transcribed, miRNA undergoes processing in the nucleus to form a double-stranded precursor that is then exported into the cytoplasm. There, the precursor is cleaved into a short RNA helix by a ribonuclease protein called dicer. The individual strands are then separated and incorporated into RNA-induced silencing complex(RISC). This multiprotein complex uses its associated miRNA as a template to bind to complementary sequences found on target mRNAs. An exact match generally results in mRNA degradation, but a partial match also causes translational repression by preventing ribosome and transcription factor binding.
Catheter

Cortisol

As a result of their immunosuppressive effects, corticosteroids such as prednisone have been used to treat many autoimmune and inflammatory conditions, including systemic lupus erythematous. However, corticosteroid use can lead to a number of adverse effects. High doses can sometimes cause corticosteroid-induced psychosis (confusion, hallucinations), as seen in this patient; hypoalbuminemia is a risk factor, and the neuropsychiatric symptoms typically resolve with discontinuation of therapy.
Corticosteroid receptors also have widespread physiologic effects, including those on circulating leukocytes and vascular endothelial cells. Neutrophil counts increase following administration of the drug as a result of "demargination" of neutrophils previously attached to the vessel wall. Therefore, neutrophil recruitment to fight infection in tissues is decreased, potentially contributing to increased infection risk.
Blood monocyte levels decrease as result of redistribution to lymph nodes.
FA Oxidation
The patient described in the question stem is most likely suffering from a peroxisomal disease. Peroxisomal diseases are rare inborn errors of metabolism where peroxisomes are either absent or nonfunctional. Very long chain and some branched chain fatty acids cannot undergo mitochondrial beta-oxidation. These fatty acids are metabolized by a special form of beta oxidation (very long chain fatty acids) or by alpha oxidation (branched chain fatty acids such as phytanic acid) within peroxisomes. When peroxisomes are absent or nonfunctional, these fatty acids accumulate within the tissues. One example of a peroxisomal disease is Zellweger syndrome. In this condition, infants are unable to properly form myelin in the CNS. Symptoms of this disease include hypotonia and seizures as mentioned in the question stem as well as hepatomegaly, mental retardation, and early death within months of initial presentation. Refsum disease results from a defect in peroxisomal alpha oxidation and leads to neurologic disturbances in response to accumulation of phytanic acid within the body. Treatment of this disease is by strict avoidance of chlorophyll in the diet.
Urticaria
Urticaria is due to increased permeability of the microvasculature, leading to edema of the superficial dermis. Involvement of the deep dermis and subcutaneous tissue is termed angioedema.
Hepatic Encehalopathy
Hepatic encephalopathy can be triggered by increased NH3 production and absorption due to:
GI bleeding: increased nitrogen load
Constipation: increased absorption
Infection: UTI, pneumonia
Increased dietary protein
Hepatic encephalopathy can be triggered by decreased NH3 clearance due to:
Transjugular intrahepatic portosystemic shunt (TIPS)
Renal failure: decreased excretion
Diuretics & hypovolemia: decreased hydration

Hemoglobin Electrophoresis

Hemoglobin electrophoresis is used to assess for different forms of hemoglobin in patients with suspected hemoglobinopathy. Normal hemoglobin consists primarily of hemoglobin A (HbA), which migrates rapidly toward the positive electrode (anode) because of its negative charge. Hemoglobin S (HbS) is an abnormal type of hemoglobin in which a nonpolar amino acid (valine) replaces a negatively charged amino acid (glutamate) in the beta globin chain. This amino acid replacement decreases the negative charge on the HbS molecule, which causes HbS to move more slowly toward the anode. Similarly, hemoglobin C (HbC) has a glutamate residue replaced by lysine in the beta globin chain. Because lysine is a positively charged amino acid, HbC has even less total negative charge than HbS and moves even more slowly toward the anode. Both HbC and HbS result from missense mutations, a type of mutation in which a single base substitution results in a codon that codes for a different amino acid.
Patients with sickle cell disease have HbS mutations in both beta chains; those with HbC disease have HbC mutations involving both beta chains. Patients with hemoglobin SC disease have 1 HbS allele and 1 HbC allele and will have 2 hemoglobin bands on electrophoresis. This patient's electrophoresis results show a single band that migrates less than the HbA and HbS bands, meaning that he has HbC disease. Patients with HbC disease are typically asymptomatic and often have mild hemolytic anemia and splenomegaly.
Parotitis

Mastocytosis
In systemic mastocytosis, clonal mast cell proliferation occurs in the bone marrow, skin, and other organs. Mast cell proliferation often is associated with mutations in the KIT receptor tyrosine kinase. These cells are characterized by prominent expression of mast cell tryptase. Excessive histamine release from degranulation of mast cells mediates many of the symptoms of the disease, such as syncope, flushing, hypotension, pruritus, and urticaria. In addition, histamine induces gastric acid secretion, which can lead to gastric ulceration. The excess acid also inactivates pancreatic and intestinal enzymes, causing diarrhea. Other gastrointestinal symptoms include nausea, vomiting, and abdominal cramps.
Receptors

Growth factors can stimulate cell proliferation by altering the expression of certain genes in the nucleus. After a growth factor binds to its cell membrane receptor, signal transduction systems transfer the signal to the nucleus. Examples of signal transduction systems include:
MAP-kinase pathway
PI3K/Akt/mTOR pathway
Inositol phospholipid pathway
cAMP pathway
JAK/STAT pathway
The PI3K/Akt/mTOR pathway is an intracellular signaling pathway that is important for cellular proliferation. This pathway is typically activated when a growth factor binds to its receptor tyrosine kinase, causing auto-phosphorylation of specific tyrosine residues within the receptor. These phosphotyrosine residues activate phosphoinositide 3-kinase (PI3K), which then phosphorylates PIP2 found in the plasma membrane to PIP3. This leads to activation of a protein called Akt (or protein kinase B), a serine/threonine-specific protein kinase. Subsequently, Akt activates mTOR (mammalian target of rapamycin), which translocates to the nucleus to induce genes involved in cell survival, anti-apoptosis, and angiogenesis. mTOR activation is inhibited by PTEN (phosphatase and tensin homolog), a tumor suppressor protein that removes the phosphate group from PIP3.
The PI3K/Akt/mTOR pathway is highly active in many cancer cells as a result of mutations causing increased activity of PI3K or Akt or loss of function of PTEN. Mutations involving certain growth factor receptors (eg, epidermal growth factor) can also enhance activity. Several drugs targeting this pathway (eg, mTOR inhibitors including rapamycin [sirolimus]) have shown benefit in treating certain cancers.
The inositol phospholipid pathway utilizes Gq proteins that stimulate hydrolysis of membrane-bound phospholipids via phospholipase C. This pathway increases cytoplasmic Ca2+ levels through IP3- mediated Ca2+efflux from the endoplasmic reticulum.
Some G protein-coupled receptors utilize cAMP as a second messenger. For example, β-adrenergic receptors activate Gs, which in turn activates adenylate cyclase and increases intracellular cAMP levels.
Most cytokine receptors lack intrinsic kinase activity and instead transduce their signals through associated intracellular tyrosine kinases known as Janus kinases (JAK). These in turn activate cytoplasmic STAT (signal transducer and activator of transcription) proteins, which dimerize and translocate to the nucleus.
Phosphodiesterases (PDE) degrade cGMP by hydrolyzing it into GMP. PDE inhibitors prevent the degradation of cGMP, thereby enhancing and prolonging its effects. For example, sildenafil enhances the vasodilatory effects of cGMP within the corpus cavernosum by inhibiting PDE 5.
Granulosa Tumor
The granulosa cells are small and cuboidal in shape, grow in cords or sheets, and form follicle- or rosette-like structures (Call-Exner bodies) that have a gland-like appearance with a pink eosinophilic center and coffee bean nuclei (black arrows). Theca cells are plump with lipid contents, which give the mass a yellow color on gross inspection.
CV Congenital Associations

Skull

OCP and IUD

DNA Pol
DNA replication requires a high degree of fidelity to preserve the genetic code in daughter cells and prevent potentially lethal mutations. This high-fidelity replication is accomplished by the 3' to 5' "proofreading" exonuclease activity of all 3 DNA polymerases.
DNA polymerase I is unique as it is the only prokaryotic polymerase that also has 5' to 3' exonuclease activity. This activity functions to remove the RNA primer created by RNA primase and repair damaged DNA sequences.
DNA polymerase III has 5' to 3' polymerase and 3' to 5' exonuclease activity; however, it does not possess 5' to 3' exonuclease activity.
Brugada
Brugada syndrome is an autosomal dominant condition that can be associated with mutations in cardiac sodium or L-type calcium channels, leading to characteristic ECG changes (eg, pseudo right bundle branch block, ST-segment elevation in leads V1-V3, negative T wave) and an increased risk of ventricular tachyarrhythmias and sudden cardiac death.
06/03/2017
Candida Risks
Common triggers for Candida vaginitis include the following:
Antibiotic use
High estrogen levels (eg, pregnancy, OCP uses)
Systemic corticosteroid therapy
Uncontrolled diabetes mellitus
Any other cause of immunosuppression, including HIV
Leukemoid Reaction
Serum leukocyte alkaline phosphatase can be normal or increased in leukemoid reaction, but it is usually low in chronic myelogenous leukemia. The peripheral smear can show Döhle bodies, which are light blue (basophilic) peripheral granules in neutrophils. The blue color is likely due to ribosomes bound with rough endoplasmic reticulum. Döhle bodies are commonly seen in toxic systemic illness but can also occur with burns or myelodysplasia. Other findings of systemic inflammation or infection include increased bands (left shift), toxic granulation, and cytoplasmic vacuoles.

Small lymphoid cells with increased nuclei to cytoplasmic ratio and cleaved nuclei are seen in certain types of lymphoma, particularly follicular lymphoma. Aka centrocytes.
Elastin

Elastin assembly is closely related to that of collagen. Similar to collagen, elastin is synthesized as a large polypeptide precursor (tropoelastin) composed of about 700, mostly nonpolar, amino acids (eg, glycine, alanine, valine). Elastin also contains proline and lysine residues; however, in contrast to those found in collagen, few of these amino acids are hydroxylated.
After tropoelastin is formed, it is secreted into the extracellular space where it interacts with microfibrils (fibrillin) that function as a scaffold. Next, lysyl oxidase (requires copper) oxidatively deaminates some of the lysine residues of tropoelastin, facilitating the formation of desmosine cross-links between neighboring polypeptides. These cross-links account for the rubber-like properties of elastin.
ROS

Antioxidant enzymes, such as superoxide dismutase, glutathione peroxidase, and catalase, convert ROS to oxygen and water, neutralizing their capacity for cellular damage. ROS generated during cellular respiration are typically neutralized by antioxidants before they become problematic. However, in the postischemic state, the production of ROS exceeds the neutralizing capabilities of antioxidant enzymes (high oxidative stress), leading to increased cell injury and death.
Myeloperoxidase is found in neutrophils and converts hydrogen peroxide to hypochlorous acid, a bactericidal compound that also causes oxidative damage to host cells.
NADPH oxidase catalyzes the reduction of molecular oxygen to superoxide free radicals, aiding in bacterial destruction by phagocytic cells.
Fibrates

Cholesterol
The first step in cholesterol synthesis is the condensation of 2 molecules of acetyl-CoA by acetyl-CoA acetyl transferase (thiolase) to form acetoacetyl-CoA. Condensation with a third molecule of acetyl-CoA yields β-hydroxy-β-methylglutaryl-CoA (HMG-CoA). HMG-CoA reductase then catalyzes the conversion of HMG-CoA to mevalonate, the rate-limiting step in cholesterol synthesis. Decreased activity of these enzymes would reduce cholesterol synthesis and the amount of cholesterol secreted in bile, discouraging cholesterol stone formation.
2,3 BPG
During normal glycolysis, ATP is generated when 1,3-BPG is converted to 3-phosphoglycerate by the enzyme phosphoglycerate kinase. However, erythrocytes can bypass this part of the pathway using bisphosphoglycerate mutase, an enzyme that converts 1,3-BPG to 2,3-BPG in a step that produces no ATP.
Use Dependence
The drug described is representative of a class I antiarrhythmic medication, which blocks voltage-gated Na+ channels. Most of the clinically useful agents bind within the pore of the channel during the open and/or inactivated states; dissociation of the drug occurs during the resting state. This state-dependent manner of binding causes a phenomenon in which tissues undergoing frequent depolarization become more susceptible to blockage (use dependence). The faster the heart rate, the more time the Na+ channels spend in the open and inactivated states and the more that become blocked.
The binding strength of class I antiarrhythmics varies between the different subclasses, with Class IB agents (eg, lidocaine) having the weakest binding compared to other class I antiarrhythmics. Dissociation from the channels occurs so rapidly that there is minimal cumulative effect over multiple cardiac cycles, resulting in little use dependence. These drugs are more selective for ischemic myocardium because the elevated (less negative) resting membrane potential delays Na+ channel transition from the inactivated to the resting state, resulting in increased drug binding. As such, class IB antiarrhythmics are useful for treating ischemia-induced ventricular arrhythmias.
In contrast, class IC agents (eg, propafenone, flecainide) have the strongest binding (Choice B). They are the slowest to dissociatefrom the channel, which allows their blocking effects to accumulate over multiple cardiac cycles. This leads to substantially greater blockade at higher heart rates (high use dependence), making them particularly effective at terminating tachyarrhythmias. However, the prominent use-dependent effects of class IC drugs can cause an excessive delay in conduction speed that can promote arrhythmias, especially in patients with ischemic or structural heart disease.
Knee Joint
Osteoarthritis causes chronic, progressive arthritis in the distal hands and weight-bearing joints. Synovial fluid analysis shows normal to minimal inflammatory findings.
Gonococcal arthritis presents with fever, skin lesions, and inflammatory mono- or oligoarthritis.
Staphylococcal septic arthritis causes a fulminant monoarthritis, usually with fever. Recurrent episodes are more characteristic of gout.
Rheumatoid arthritis causes a chronic polyarthritis, typically involving the metacarpophalangeal joints of the hands. Synovial fluid will show a sterile inflammatory effusion.
Nontraumatic hemarthrosis is most commonly seen in patients taking anticoagulants (eg, warfarin) or with bleeding disorders (eg, hemophilia).
Crystal arthritis due to alcium pyrophosphate deposition (pseudogout) most commonly affects the knee and is often similar to gout. However, it is less common and not associated with myeloproliferative disorders.
Meckel

Cardiac Ischemia

Pap Smear
aka cervical cytology
Brain AVM
Brain arteriovenous malformations are developmental vascular lesions that usually present at age 10-30 with intracranial hemorrhage, seizure, headache, or focal neurologic deficits.

Dandy Walker

This child likely has Dandy-Walker malformation, a developmental anomaly characterized byhypoplasia/absence of the cerebellar vermis (red arrow) and cystic dilation of the fourth ventricle with posterior fossa enlargement (blue arrow).
Patients often present during infancy with developmental delay and progressive skull enlargement. Cerebellar dysfunction can result in unsteadiness and impaired muscle coordination. Non-communicating hydrocephalus may occur due to atresia of the foramina of Luschka and Magendie, resulting in symptoms of elevated intracranial pressure (eg, irritability, vomiting). Other associated features can include agenesis of the corpus callosum and malformations involving the face, heart, or limbs.
Holoprosencephaly

Patau, Shh mutation, alcohol
occurs at 5 weeks
It is an example of a developmental field defect, which is when an initial embryonic disturbance leads to multiple malformations by disrupting the development of adjacent tissues and structures within a particular region.
Congenital Defects
Agenesis refers to the complete absence of an organ. Renal agenesis, the congenital absence of one or both kidneys, is an example of this type of abnormality.
An association refers to multiple anomalies without a known unifying cause that occur together more frequently than chance alone would predict. Vertebral defects, anal atresia, cardiac defects, tracheo-esophageal fistula, renal anomalies, and limb abnormalities (VACTERL) are an example of an association of anomalies without a known common etiology.
Deformations are fetal structural anomalies that occur due to extrinsic mechanical forces. The pressure applied by the uterus is one of the most common deforming forces. For example, uterine constraint on a fetus in breech position can cause developmental dysplasia of the hip, a condition marked by abnormal development of the femoral-acetabular junction and subsequent hip instability.
Dysplasia describes abnormal organization of cellular architecture within a tissue. Osteogenesis imperfecta, a skeletal disorder characterized by brittle bones that fracture easily, occurs with dysplasia of connective tissue due to absent or abnormal type I collagen.
Cardiac Hypertrophy

Mitral insufficiency causes LV volume overload as regurgitant flow through the mitral valve during systole increases the amount of blood returning to the LV during diastole. The net structural consequence of mitral insufficiency is enlargement of the LV cavity and eccentric hypertrophy.
Mitral stenosis leads to left atrial enlargement due to elevated pressure in the left atrium. The LV cavity is typically small/normal in size with normal wall thickness due to restriction of blood flow across the mitral valve.
Mosaicism


Insulin

Hip Muscles
Flexion
Extension
Abduction
Adduction
• Iliopsoas• Rectus femoris• Tensor fascia lata
• Gluteus maximus• Semitendinosus• Semimembranosus• Biceps femoris - long head
• Gluteus medius• Gluteus minimus
• Adductor brevis• Adductor longus• Adductor magnus
Crohn Stones
Loss of bile acids causes impaired fat absorption. The excess lipids in the bowel lumen bind to calcium ions, and these soap complexes are then excreted with the feces.
In the healthy bowel, dietary calcium binds to dietary oxalate, producing insoluble calcium oxalate salts that promote oxalate excretion. In Crohn disease, calcium binds to lipids instead and becomes unavailable for complexing with oxalate. As a result, oxalate absorption is increased, promoting the formation of oxalate kidney stones (enteric oxaluria).
IP3

G protein-coupled receptors have a characteristic structure with 7 transmembrane regions, an extracellular domain, and an intracellular domain coupled with a G protein. In their inactivated state, G proteins exist as heterotrimers consisting of alpha, beta, and gamma subunits with GDP tightly bound to the alpha subunit. G proteins are activated after ligand binding to the extracellular domain of the receptor. The first step in activation occurs when GDP is exchanged for GTP on the alpha subunit. Once bound to GTP, the alpha subunit dissociates from the beta and gamma subunits and activates either adenylate cyclase or phospholipase C, depending on the ligand.
When phenylephrine binds to an alpha-1 receptor on vascular smooth muscle cells, the alpha subunit of the G protein (Gq) activates phospholipase C, which breaks down phosphatidylinositol bisphosphate into inositol triphosphate (IP3) and diacylglycerol (DAG). DAG stimulates protein kinase C, which phosphorylates downstream intracellular proteins to produce its physiologic effects (eg, smooth muscle contraction). IP3 produces most of its effects by increasing intracellular calcium, which also activates protein kinase C. In the study described above, protein kinase C activity would be reduced in the experimental group compared to the control group as calcium release from the endoplasmic reticulum is interrupted.
Pulmonary Anastomosis

Confidence Interval
A statistically significant 95% CI corresponds to a p-value <0.05; a statistically significant 99% CI (would also not include the null value and likely be wider than a 95% CI) corresponds to a p-value <0.01.

Cervical Subluxation
This patient with rheumatoid arthritis underwent urgent endotracheal intubation due to severe pneumonia and subsequently developed sudden-onset quadriparesis. Long-standing rheumatoid arthritis frequently involves the cervical spine and causes joint destruction with vertebral malalignment (subluxation). The atlantoaxial joint is most often involved as the atlas (C1) has a high degree of mobility relative to the axis (C2 odontoid and body).
Chronic symptoms of cervical subluxation include neck pain, stiffness, and neurologic findings (eg, sensory loss, muscle weakness). Endotracheal intubation can acutely worsen the subluxation and cause compression of the spinal cord and/or vertebral arteries. Acute spinal cord injury results in flaccid paralysis with decreased or absent reflexes below the level of the compression due to spinal shock; the paralysis eventually becomes spastic as spinal shock resolves over the ensuing days to weeks.
Leukocytoclastic Vasculitis
Cutaneous small vessel vasculitis is a vasculitis that only affects the skin and typically arises due to drug or pathogen exposure (eg, hepatitis B or C virus). Drugs known to cause this condition include penicillins, cephalosporins, sulfonamides, phenytoin, and allopurinol. On skin examination, nonblanching palpable purpura is usually present and often involves the lower extremities. When biopsied, these skin lesions histologically demonstrate markedly inflamed small blood vessels with fibrinoid necrosis. In the first 24 hours, the perivascular inflammatory cell population consists primarily of neutrophils and fragmented neutrophilic nuclei (leukocytoclastic vasculitis), with mononuclear cells predominating in older lesions.
Reye
Light microscopy of a liver biopsy shows microvesicular steatosis, the presence of small fat vacuoles in the cytoplasm of hepatocytes. No necrosis or inflammation is present in the liver. Electron microscopy findings include swelling, a decreased number of mitochondria and glycogen depletion.
PNMT and Cortisol
Expression of PNMT in the adrenal medulla is upregulated by cortisol. Because the venous drainage of the adrenal cortex passes through the adrenal medulla, cortisol concentrations in the medulla can be very high, and PNMT is expressed at a high level. However, following pituitary resection, ACTH secretion and subsequent cortisol production would be low. The result would be decreased PNMT activity and reduced conversion of norepinephrine to epinephrine.
Sore

Hepatobiliary Scan
Ultrasonography is the preferred initial imaging test for the diagnosis of acute cholecystitis; however, nuclear medicine hepatobiliary scanning (ie, cholescintigraphy) can be an alternate means when ultrasonography is inconclusive. During a hepatobiliary scan, a radiotracer is administered intravenously and is preferentially taken up by hepatocytes and excreted into bile. Images of the tracer as it moves through the hepatobiliary system and intestine are then obtained for up to several hours after injection.

In patients with a patent cystic duct, the gallbladder will be seen as the radiotracer accumulates and concentrates within (image C). In acute or chronic cholecystitis, the radiotracer will be taken up by the liver with progressive excretion into the common bile duct and proximal small bowel, but the gallbladder will not be visualized due to the obstruction (image A and B).
Monometer

Shoulder Muscles
The latissimus dorsi is innervated by the thoracodorsal nerve, with fibers originating from the C6-8 nerve roots. Primary functions include extension, adduction, and internal rotation of the humerus.
Due to its broad area and exposed location, the latissimus dorsi is vulnerable to injury from external trauma. It is also frequently injured in sports requiring forceful downward movement of the humerus, such as throwing, climbing, or swinging a tennis racket overhead.
The trapezius is a large muscle in the upper back and neck that serves to elevate, rotate, and stabilize the scapula. It is primarily innervated by cranial nerve XI. The trapezius is frequently injured in rear-end ("whiplash") motor vehicle accidents.
Dissociative
Dissociative amnesia involves gaps in autobiographical memory. Dissociative identity disorder is a rare condition associated with severe trauma that involves fragmentation of identity into ≥2 distinct personality states.
HPL
This increase in insulin resistance is primarily due to the action of human placental lactogen (hPL), a peptide hormone secreted by the syncytiotrophoblast.
Cyanide
Cyanide poisoning presents with reddish skin discoloration, tachypnea, headache, and tachycardia, often accompanied by nausea/vomiting, confusion, and weakness. Symptoms develop rapidly and can quickly progress to seizures and cardiovascular collapse. Laboratory studies indicate severe lactic acidosis in conjunction with a narrowing of the venous-arterial PO2 gradient, resulting from the inability of tissue to extract arterial oxygen.
Administration of inhaled amyl nitrite oxidizes ferrous iron (Fe2+) present in hemoglobin to ferric iron (Fe3+), generating methemoglobin. Methemoglobin is incapable of carrying oxygen but has a high affinity for cyanide; it binds and sequesters cyanide in the blood, freeing it from cytochrome oxidase and limiting its toxic effects. Hydroxycobalamin, a vitamin B12 precursor, and sodium thiosulfate are also antidotes for cyanide poisoning. Their interactions with cyanide generate relatively nontoxic metabolites that are easily excreted in the urine.

Diffused Esophageal Spasm
This patient's presentation is consistent with diffuse esophageal spasm (DES). Esophageal contractions are normally stimulated by esophageal distension from a food bolus. The contractions originate above the site of distension and propel the bolus downward in a coordinated fashion. In DES, several segments of the esophagus contract inappropriately at the same time, which appears as disorganized non-peristaltic contractions on esophageal manometry and "corkscrew" esophagus on barium esophagogram. Because the food bolus is inefficiently propelled toward the stomach, patients typically present with intermittent solid/liquid dysphagia, chest pain, heartburn, and food regurgitation. The pathogenesis of DES likely involves impaired inhibitory neurotransmission within the esophageal myenteric plexus.
Lipid Lowering

Administration of hydrophilic bile acids (eg, ursodeoxycholic acid) reduces cholesterol secretion and increases biliary bile acid concentration. This improves cholesterol solubility and promotes gallstone dissolution.
Retinal Artery

Retinal artery occlusion (RAO) is an important cause of acute, painless, monocular vision loss. Thromboembolic complications of atherosclerosis in the internal carotid are the most common cause of RAO. The retinal artery is one of the first branches of the ophthalmic artery, which receives its supply from the internal carotid.
Nausea

This patient's nausea, vomiting, and watery diarrhea are typical symptoms of classic travelers' diarrhea (TD). TD can be caused by a variety of organisms, including bacteria (eg, Escherichia coli), viruses (eg, rotaviruses), or occasionally, parasites (eg,Cryptosporidium parvum). In most cases, the illness is self-limited and treatment is symptomatic.
The choice of antiemetic therapy depends on the source of the emetogenic stimulus. Conditions that cause gastrointestinal irritation (eg, infections, chemotherapy, distention) result in increased mucosal serotonin release and activation of 5-HT3 receptors on vagal and spinal afferent nerves. These then relay their impulses to the medullary vomiting center, inducing emesis. 5-HT3 receptor antagonists (eg, ondansetron) are well-tolerated medications that are very effective at reducing nausea and vomiting caused by gastrointestinal upset.
Loperamide is a µ-opioid receptor agonist that functions as an antimotility agent. It is commonly used in TD to reduce diarrhea but can worsen nausea and vomiting due to colonic retention.
Dopamine receptor antagonists (eg, metoclopramide, prochlorperazine) are effective in treating central nausea (seen in acute migraines) and also reduce migraine headache pain. Dopamine antagonists have significant adverse effects including sedation and extrapyramidal symptoms; these are not the first-line treatment for nausea due to gastrointestinal upset.
First-generation H1 receptor antagonists (eg, diphenhydramine, meclizine) and muscarinic acetylcholine receptor antagonists (eg, scopolamine) are frequently used to treat vestibular nausea (eg, motion sickness). Promethazine is a dopamine and H1 receptor antagonist that can also treat vestibular nausea. All of these medications can cause significant sedation.
NFKB

Nuclear factor-kappa B (NF-κB) is part of a family of transcription factors that perform a critical role in the immune response to infection and inflammation. In inflammatory cells, NF-κB is normally present in a latent, inactive state bound to its inhibitor protein, IκB. As part of the classical activation pathway, an extracellular signal, such as the binding of bacterial antigens to a toll-like receptor, causes activation of IκB kinase. This results in ubiquitination and subsequent destruction of IκB with the release of free NF-κB. Once free, NF-κB enters the nucleus and promotes the synthesis of a number of inflammatory proteins such as cytokines, acute phase reactants, cell adhesion molecules, and leukocyte-related growth factors. The inflammatory cascade is self-limiting as NF-κB also stimulates the transcription of more IκB, ultimately rebinding the freed NF-κB.
Consent
Circumstances in which minors do not require consent:
Medical circumstances:
Emergency care
Sexually transmitted infections
Substance abuse (most states)
Prenatal care (most states)
Contraception
Emancipated minor:
Homeless
Parent
Married
Military
Financially independent
High school graduate
Two-thirds of states require parental consent prior to abortion; one-third require parental notification, but not consent.
Polyps
This patient has a large mass with high-grade dysplasia. It has long glands with villi-like projections extending from the surface, which is characteristic of a villous adenoma. Villous adenomas are often large and sessile and can have velvety or cauliflower-like projections.
By contrast, tubular adenomas are composed of dysplastic colonic mucosal cells that form tube-shaped glands and tend to be smaller and pedunculated:

Tubulovillous adenomas contain a mixture of the 2 types. Of these, villous adenomas are the most likely to undergo malignant transformation:

Adenomas in the colon can cause occult or visible bleeding, leading to iron-deficiency anemia. Large polyps may occasionally cause partial obstruction with pain, constipation, and abdominal distension. In addition, villous adenomas can secrete large quantities of watery mucus, leading to secretory diarrhea, hypovolemia, and electrolyte abnormalities.
Intestinal carcinoids can cause diarrhea and are often associated with additional symptoms such as flushing, wheezing, and vascular telangiectasia when they metastasize. Histopathology is typified by insular and trabecular masses of monotonous small round cells with peripheral palisading, finely granular cytoplasm, small nucleoli, and salt and pepper chromatin.

Hamartomatous polyps consist of disorganized mucosal glands, smooth muscle, and connective tissue. They may occur sporadically or in Peutz-Jeghers syndrome or juvenile polyposis. These polyps can cause bleeding and intussusception, but not secretory diarrhea.

Scurvy
This patient with perifollicular hemorrhages, myalgias, subperiosteal hematoma, and gingivitis has typical features of scurvy. Scurvy, which is due to a deficiency of ascorbic acid (vitamin C), is uncommon in developed countries as this vitamin is widely available in fruits, vegetables, and a variety of other foods. However, it may occasionally be seen in patients with abnormal eating patterns, including the elderly, alcoholics, and persons who live alone. Other possible signs of scurvy include hemarthrosis, petechial hemorrhages, impaired wound healing, and weakened immune responses to local infections.

Gaucher

Lung Abscess

06/04/2017
Scurvy
In the United States, vitamin C deficiency (scurvy) is most often seen in severely malnourished individuals (eg, homeless, alcohol or drug abusers). Symptoms of vitamin C deficiency are the result of decreased connective tissue strength. The capillary walls are especially fragile, leading to easy bruising, mucosal bleeding, and perifollicular petechial hemorrhages. Patients may also suffer from periodontal disease (gum swelling, loosening of the teeth, and infection) and poor wound healing, and have hyperkeratotic follicles with corkscrew hairs. Scurvy is even more severe in children and manifests with hemorrhages, bony deformities, and subperiosteal and joint hematomas.
Vitamins

Bone Disorders
The skeletal findings in hyperparathyroidism most commonly involve the cortical (compact) bone in the appendicular skeleton (the pectoral girdle, pelvic girdle, and limbs). Subperiosteal thinning is a characteristic feature and appears radiologically as subperiosteal erosions in phalanges of the hand, a granular "salt-and-pepper" skull, and osteolytic cysts in the long bones (osteitis fibrosa cystica).
Disorganized lamellar bone structure in a mosaic pattern is a characteristic finding of Paget disease of bone. Serum calcium and phosphorous are normal in these patients.
Osteoid matrix accumulation around trabeculae is seen in vitamin D deficiency. Histologically, there is excessive un-mineralized osteoid with widened osteoid seams. Patients will typically have low urinary calcium.
Persistence of the primary spongiosa in the medullary cavity with no mature trabeculae is a classic finding in osteopetrosis (ie, "marble bone disease"). Osteopetrosis is caused by decreased osteoclastic bone resorption, which results in accumulation of woven bone and diffuse skeletal thickening.
Trabecular thinning with fewer interconnections is characteristic of osteoporosis. Although longstanding PHP causes thinning of cortical bone, the trabecular architecture remains relatively preserved.
mRNA

Churg Strauss
This patient most likely has eosinophilic granulomatosis with polyangiitis (Churg-Strauss). This small to medium vessel vasculitis is characterized by late-onset asthma, rhinosinusitis, and eosinophilia, though it can involve many other organ systems including the kidneys, gastrointestinal tract, and cardiovascular system. Asymmetric multifocal neuropathy (mononeuritis multiplex) is particularly common due to the vasculitis affecting the epineural vessels (eg, wrist drop due to radial nerve involvement). Other common manifestations include skin nodules, migratory/transient pulmonary infiltrates, and paranasal sinus abnormalities. In addition to peripheral eosinophilia, a frequent laboratory finding is antibodies against neutrophil myeloperoxidase, which most commonly have a pattern of perinuclear staining (p-ANCA).
TB

CF Vs Hirschsprung

HD typically presents with increased rectal tone, "squirt sign" (forceful expulsion of stool after rectal examination)
Carcinoid and Appendicitis
Carcinoid tumors are malignant transformations of neuroendocrine cells, most commonly located in the gastrointestinal tract (eg, small intestine, rectum, appendix), followed by the bronchopulmonary system. The majority of appendiceal carcinoids have a benign clinical course. They are usually found at the tip of the appendix in asymptomatic patients who have undergone appendectomy for unrelated reasons. Tumors at the base of the appendix may cause obstruction and appendicitis. In rare cases, large tumors will metastasize to the liver, causing carcinoid syndrome (flushing, diarrhea, bronchospasm).
mRNA polycistronic
Polycistronic mRNA is often found in bacteria and contains multiple open reading frames that are translated into several proteins. In contrast, eukaryotic organisms have monocistronic mRNA, which codes for only one protein.
Thrombophlebitis
Migratory thrombophlebitis should raise suspicion for cancer. Hypercoagulability is a very common paraneoplastic syndrome seen most frequently in visceral adenocarcinomas of the pancreas, colon, and lung. Hypercoagulability develops because adenocarcinomas produce a thromboplastin-like substance capable of causing chronic intravascular coagulations that can disseminate and tend to migrate.
Serratus Anterior
The serratus anterior originates on the surface of the first 8 ribs and inserts on the medial border of the scapula. It functions to stabilize and rotate the scapula upward.
Injury to the nerve can occur during penetrating trauma or iatrogenically during axillary lymph node dissection or chest tube insertion.
Collagen Synthesis

Proteoglycans
Proteoglycans are composed of glycosaminoglycans (GAGs), which provide compressibility to tissues. Patients with deficiencies in lysosomal enzymes cannot break down GAGs, resulting in mucopolysaccharidoses (eg, Hurler syndrome, Hunter syndrome) characterized by soft tissue and skeletal disease.
Neuronal Injury

An axonal reaction occurs when a neuron's axon is severed. This reaction entails swelling of the cell body, movement of the nucleus to the periphery and the dispersion of Nissl substance.
Fructokinase Deficiency
Fructose, similar to glucose and galactose, is a reducing sugar and can be detected by a copper reduction test, which nonspecifically detects the presence of reducing sugar. A urine dipstick, however, uses glucose oxidase to ascertain the presence of urinary glucose and will not test positive in the presence of fructose or galactose.
VOMIT

Alzheimer
Alzheimer disease is the most common cause of dementia. It has the following characteristic features:
Prevailing clinical symptom: slow, progressive memory loss.
Macroscopic brain appearance: mild-to-moderate generalized brain atrophy.
Microscopic brain changes: neurofibrillary tangles, senile plaques, and amyloid angiopathy.
Biochemical abnormalities: decreased acetylcholine levels in the hippocampus and nucleus basalis of Meynert.
The most important biochemical abnormality noted in Alzheimer disease is a decrease in acetylcholine level. This occurs due to the deficiency of choline acetyltransferase. The decline in acetylcholine levels is most notable in the basal nucleus of Meynert, which participates in memory and cognition. This nucleus is located at the base of the forebrain and widely projects to the neocortex. Another involved structure is the hippocampus: the major function of the hippocampus is formation of new memories.
Medications that diminish the degradation of acetylcholine palliate the symptoms of Alzheimer disease.
Councilman Bodies
Apoptotic hepatocytes form round acidophilic (pink-staining on H&E) bodies known as Councilman bodies or apoptotic bodies.
PPV

Important parameters of diagnostic tests include the following:
True positives (TP) represent diseased individuals with positive test results.
True negatives (TN) represent healthy individuals with negative test results.
False positives (FP) represent healthy individuals with positive test results.
False negatives (FN) represent diseased individuals with negative test results.
Sensitivity (TP/ [TP + FN]) represents a test's ability to correctly identify diseased individuals from among all individuals. A test with high sensitivity has a low FN rate (important for screening purposes). With a highly sensitive test, most diseased patients will have a positive test result (and anegative test result would help rule out the disease [SnNOut]).
Specificity (TN/ [TN + FP]) represents the ability of a test to exclude those without the disease. A very specific test has a low FP rate (important for confirmatory tests). With a highly specific test, most healthy patients will have a negative test result (and a positive test result would help rule in the disease [SpPIn]).
The cutoff value of a quantitative diagnostic test determines whether a given result is interpreted as positive or negative. Depending on the disease or condition being tested for, sensitivity or specificity may be preferred and the cutoff value adjusted accordingly. A cutoff value just outside the overlapping region of the curves can maximize the sensitivity or specificity at 100% by correctly classifying all diseased or healthy individuals, respectively.
In the above example, changing the cutoff point to a lower value (shift to the left) would cause more patients with the disease to test positive (↑TP, ↓FN), increasing the sensitivity of the test. However, as a consequence, more patients without the disease would also test positive (↓TN, ↑FP), resulting in decreased specificity.
Lysosomal Storage Diseases

Fabry

Gb3 accumulation in vascular smooth muscle cells, glomerular/distal tubule cells, cardiac myocytes, and dorsal root and autonomic ganglia accounts for the adverse manifestations of Fabry disease.
The earliest symptoms present during adolescence and include neuropathic pain and hypohidrosis(decreased sweating). Small-fiber nerve involvement results in severe distal extremity pain and burning as well as distal loss of hot/cold temperature sensation. Exacerbating factors include exercise, stress, and fatigue. In late adolescence, angiokeratomas and telangiectasias develop on the skin. Angiokeratomas are dark red, non-blanching macules and papules that classically occur in clusters over the buttocks, groin, and umbilicus.
In early and mid-adulthood, cerebrovascular (eg, transient ischemic attack, stroke) and cardiac (eg, left ventricular hypertrophy) diseases develop and are the most common causes of death. In addition, Gb3 buildup in the glomerulus and distal tubule results in proteinuria and polyuria, respectively, and can progress to renal failure in the absence of enzyme replacement therapy.
Alzheimer treatment
Regarding the other classes of AD drugs, vitamin E (α-tocopherol) is a neuroprotective agent that may slow functional losses in AD. Memantine is a NMDA receptor antagonist. It is thought that CNS NMDA-receptor overstimulation by glutamate may contribute to AD symptoms.
Histology
Fibroma:

Fibrosarcoma:

Leiomyoma:

Leiomyosarcoma:

Iron

AAT Emphysema

Adenocarcinoma
On gross examination, signet-ring carcinomas are characterized by diffuse involvement of the stomach wall (due to loss of the cell adhesion protein E-cadherin). They have a plaquelike appearance, are ill-defined, and often infiltrate large areas of the stomach wall, causing a "leather-bottle stomach" (linitis plastica).
Gastrinoma vs Menetrier
Rugal thickening with acid hypersecretion is a characteristic finding in the stomach of a patient with Zollinger-Ellison syndrome. Rugal hypertrophy with parietal cell atrophy and decreased acid secretion occurs with Ménétrier disease.
RAS

RAS genes code for a family of small G-proteins involved in signal transduction in the Ras-MAPK pathway. Ras proteins exist in 2 different states: an inactive GDP-bound state and an active GTP-bound state. Ras becomes activated when a growth factor ligand binds to a receptor tyrosine kinase located on the cell membrane, causing autophosphorylation of the receptor. This triggers binding of adaptor proteins that interact with Ras, promoting GDP removal and GTP binding. Activated Ras then begins a phosphorylation cascade that results in the activation of mitogen-activated protein kinase (MAPK), which enters the nucleus to influence gene transcription.
Ras proteins have intrinsic GTPase activity that allows them to hydrolyze GTP; this mechanism prevents accumulation of active Ras (GTP-bound) in the absence of hormonal signaling. RAS gene mutations can lead to decreased intrinsic GTPase activity; this results in a constitutively activated Ras protein that causes constant and unregulated cell proliferation. RAS mutations are commonly identified in cancerous tumors, specifically colorectal and pancreatic malignancies.
12th Rib

Friedreich

Spinocerebellar and lateral corticospinal tract degeneration causes gait ataxia and spastic muscle weakness, respectively.
Degeneration of the dorsal columns and dorsal root ganglia causes loss of position and vibration sensation.
Kyphoscoliosis and foot abnormalities (pes cavus) are characteristic skeletal deformities.
Heart involvement includes hypertrophic cardiomyopathy and congestive heart failure.
Diabetes mellitus develops in about 10% of patients with Friedreich ataxia.
Charcot-Marie-Tooth disease is an autosomal dominant disorder associated with demyelination of peripheral nerves. Typical findings include distal leg weakness/atrophy with sensory deficits, pes cavus, and kyphoscoliosis; cardiomyopathy is not characteristic.
Virus

This patient's presentation after recent travel to Brazil is consistent with dengue fever (DF). DF is due to a virus transmitted by the Aedes aegypti**mosquito**. It is prevalent in tropical and subtropical regions (South and Southeast Asia, Pacific Islands, Caribbean, Americas). DF presents as an acute febrile illness with headache, retro-orbital pain, and joint and muscle pain. Other findings can include hemorrhage (eg, petechiae, purpura, epistaxis, melena), thrombocytopenia, leukopenia, and hemoconcentration.
The Aedes mosquito also transmits the virus causing chikungunya, a febrile illness with flulike symptoms, prominent polyarthralgia/arthritis (hands, wrists, ankles), and diffuse macular rash. As a result, many areas have had simultaneous outbreaks of both dengue and chikungunya. Preventive measures against both infections include protective barriers (eg, bed nets, window screens) and insect spraying.
Eosinophil Esophagitis
Eosinophilic esophagitis is an immune/antigen-mediated disease that typically presents with dysphagia and food impaction in atopic adults. It is characterized histologically by numerous superficially located intraepithelial eosinophils, which can help differentiate it from reflux esophagitis. In addition, proton pump inhibitors (eg, pantoprazole) do not usually result in symptomatic improvement.
Aa gradient

Enzyme Locations
The cytosol and mitochondria are the predominant sites of metabolism in the cell. Mitochondria are the site of beta-oxidation of fatty acids, the citric acid cycle, and the carboxylation of pyruvate (gluconeogenesis). The cytosol is home to enzymes necessary for glycolysis, fatty acid synthesis, and the pentose phosphate pathway.
Ornithine transcarbamylase catalyzes the combination of ornithine and carbamoyl phosphate to form citrulline in the urea cycle. This reaction occurs within the mitochondria.
Turner SHOX
The loss of all or part of the X chromosome in Turner syndrome results in a missing SHOX gene, which normally promotes long bone growth. Therefore, patients with this syndrome typically have short stature.
Diabetes Insipidus

Base Exision Repair

tRNA

The acceptor stem is created through the base pairing of the 5'-terminal nucleotides with the 3'-terminal nucleotides. The CCA tail hangs off the 3' end, with the amino acid bound to the 3' terminal hydroxyl group. tRNA is "loaded" with the appropriate amino acid by aminoacyl tRNA synthetase. The acceptor stem helps mediate correct tRNA recognition by the proper aminoacyl tRNA synthetase.
A 3' CCA tail is added to the 3' end of tRNA as a posttranscriptional modification in eukaryotes and most prokaryotes. Several enzymes utilize this tail to help recognize tRNA molecules.
The D loop contains numerous dihydrouridine residues, which are modified bases often present in tRNA. The D loop (along with the acceptor stem and anticodon loop) facilitates correct tRNA recognition by the proper aminoacyl tRNA synthetase.
The anticodon loop contains sequences that are complementary to the mRNA codon. During translation, the ribosome complex selects the proper tRNA based solely on its anticodon sequence.
The T loop contains the TΨC sequence that is necessary for binding of tRNA to ribosomes. The TΨC sequence refers to the presence of ribothymidine, pseudouridine, and cytidine residues.
Fomepizole

Marfan vs Homocystinuria

AA derivatives

SHS

Bohr, Haldane
In the peripheral tissues, the release of O2 from hemoglobin is enhanced by increased pCO2 and the resultant decrease in pH (Bohr effect). This effect occurs due to the histidine side chains found on the alpha and beta hemoglobin subunits. As the tissues release CO2, the majority is converted by erythrocyte carbonic anhydrase to bicarbonate and H+. While bicarbonate is shifted out of the erythrocytes in exchange for chloride ions found in the plasma, the hydrogen ions remain within the erythrocytes. These hydrogen ions are buffered by the histidine residues on hemoglobin and in the process, help stabilize the deoxygenated form of hemoglobin and decrease its affinity for oxygen.

When deoxygenated blood enters the alveolar capillaries of the lung, the rise in pO2 increases the binding of oxygen to hemoglobin and causes the release of H+ and CO2 from hemoglobin (Haldane effect). As bicarbonate shifts back into the erythrocytes in exchange for chloride, carbonic anhydrase converts H+ and bicarbonate ions back into CO2 and water. The CO2 is then excreted through the lungs.
Haemophilus vs Neisseria
Pharynx → lymphatics → meninges: This is the mechanism of spread of Haemophilus influenzae meningitis. Infants and young children are most commonly affected. Compare this to Neisseria that spread from pharynx to blood.
Traumatic wound → leaking CSF → meninges: This is the most common cause of S. aureusmeningitis or CNS abscess. Following penetrating skull trauma or neurosurgery, S. aureus from the skin is introduced into the CNS.
Traction Diverticuli
Traction diverticula are created by inflammation and subsequent scarring of the gut wall, which typically results in pulling and outpouching of all gut wall layers (true diverticula). This may occur in the midesophagus due to mediastinal lymphadenitis caused by tuberculosis or fungal infection.
Ansa Cervicalis
The ansa cervicalis is a loop of the cervical plexus that receives contributions from C1-C3. It courses deep to the sternocleidomastoid muscle and loops around the internal jugular vein. Branches from the ansa cervicalis innervate the sternohyoid, sternothyroid, and omohyoid muscles.
Inferior Thyroid Artery

Unilateral nerve injury often causes hoarseness, whereas bilateral injury may cause inspiratory stridor and respiratory distress due to complete vocal cord paralysis.
Superior Laryngeal Nerve
The superior laryngeal nerve branches off the vagus nerve high in the neck and divides into an external branch that supplies the cricothyroid muscle and an internal branch that provides sensation over the supraglottic area. The external branch of this nerve may be misligated during thyroid surgery due to its proximity to the superior thyroid artery.
ARDS
During the first 1-6 days, interstitial and intraalveolar edema, inflammation, and fibrin deposition cause the alveoli to become lined with waxy hyaline membranes (see image above). These membranes consist of fibrin exudate and inspissated protein-rich edema fluid mixed with the remnants of necrotic epithelial cells.
Anovulatory Cycle

In most women age 20-40 years, menstrual cycles are consistent and last 24-35 days, with menstrual flow ranging from 4-6 days. However, adolescents typically have an immature hypothalamic-pituitary-ovarian axis for several years following menarche. During this time, they may have longer menstrual cycles and irregular bleeding patterns due to the presence of anovulatory cycles. In the absence of ovulation, the ovarian follicle does not degenerate and become a corpus luteum. As a result, no progesterone is produced and estrogen levels remain persistently high, causing the endometrium to remain in the proliferative phase. Chronically proliferative endometrium becomes disorganized and fragile with unstable venous capillaries, resulting in irregular periods of stromal breakdown with variable, but often heavy, bleeding.
06/05/2017
Facial Development

Follicular Lymphoma
Follicular lymphoma is the most common indolent non-Hodgkin lymphoma (NHL) in adults and the second most common NHL overall. It derives from follicular B cells and typically has a long, waxing and waning clinical course. This condition most often presents in middle-aged patients with painless lymph node enlargement or abdominal discomfort from an abdominal mass.
Diffuse large B-cell lymphoma (most common NHL) typically presents with a rapidly enlarging nodal (neck, abdomen, mediastinum) or extranodal symptomatic mass. The Waldeyer's ring (oropharyngeal lymphoid tissue) and gastrointestinal tract are commonly involved, and systemic "B" symptoms (fever, weight loss, drenching night sweats) can also be seen.
Cricothyroidectomy

Skin
Superficial cervical fascia (including subcutaneous fat and platysma muscle)
Investing and pretracheal layers of the deep cervical fascia
Cricothyroid membrane
Ureter Injury
This patient has a right ureteral injury, a rare but serious complication of pelvic surgery presenting with flank pain and fever.
The ureter is most vulnerable to injury during a hysterectomy, where the damage can occur at the point of ligation of the uterine vessels and closure of the lateral aspects of the vaginal cuff. A transection injury of the ureter causes localized leakage of urine as well as flank pain. Since the second ureter is uninjured, patients are able to void (urinate) normally. Bilateral ureteral injury is extremely unlikely and would result in anuria and bilateral flank pain.
Pudendal Block
Important landmarks for a PN block include the ischial spines and sacrospinous ligament. The ischial spines are bony protrusions located posterolateral to the vaginal sidewall. The sacrospinous ligament is a firm band that runs medially and posteriorly from the ischial spine to the sacrum. When administering a PN block, the ischial spines should be palpated intravaginally, and the anesthetic should be injected medially in very close proximity to the ischial spine through the sacrospinous ligament.
Cephalosporin
Penicillins and cephalosporins function by irreversibly binding to penicillin-binding proteins. Transpeptidases are one form of penicillin-binding protein that function to cross-link peptidoglycan in the bacterial cell wall. Inhibition of transpeptidase (which occurs with the use of the cephalosporin ceftriaxone) leads to cell wall instability and bacteriolysis.
Vancomycin binds to the terminal D-alanine residues of cell wall glycoproteins and prevents transpeptidases from forming cross-links.
Protein

Strep
S pyogenes is a pyrrolidonyl arylamidase (PYR)-positive, beta-hemolytic, Gram-positive cocci that grows in chains.
Erosions

Gastric erosions are defined as mucosal defects that do not fully extend through the muscularis mucosa (ie, erosions are limited to the mucosal layer). Gastric ulcers, on the other hand, penetrate through the mucosal layer and extend into the submucosal layers.
Biliary Sludge
This patient's slow/incomplete gallbladder emptying in response to cholecystokinin stimulation is consistent withgallbladder hypomotility. The gallbladder functions to actively absorb water from bile; conditions that cause gallbladder hypomotility result in excessive dehydration of bile. This promotes the precipitation and accumulation of particulate material (eg, cholesterol monohydrate crystals, calcium bilirubinate, mucus) in bile, forming viscousbiliary sludge. Sludge formation may be asymptomatic or cause biliary colic (right upper quadrant abdominal pain associated with nausea) and is a known precursor to stone formation (particularly cholesterol stones). Complications such as acute cholecystitis and cholangitis can also occur in patients with biliary sludge.
Pudendal

Prostate

The prostatic plexus lies within the fascia of the prostate and originates from the inferior hypogastric plexus (which itself is a continuation of the hypogastric nerve with additional input from the pelvic and sacral splanchnic nerves). The lesser and greater cavernous nerves arise from the prostatic plexus and pass beneath the pubic arch to innervate the corpora cavernosa of the penis and urethra. The cavernous nerves carry post-ganglionic parasympathetic fibers that facilitate penile erection. Prostatectomy or injury to the prostatic plexus can cause erectile dysfunction; as a result, surgeons attempt to preserve the integrity of the prostatic fascial shell during surgery.
Media
Differential media help identify cultured organisms based on their metabolic and biochemical properties. Examples of differential media include the MacConkey and eosin methylene blue (EMB) agars used to culture enteric organisms. Organisms that ferment lactose will appear pink on MacConkey agar and black on EMB agar.
Enrichment media contain special growth factors required for some organisms. Examples include the X and V factors required by Haemophilus or the anaerobic conditions needed by Clostridium species.
Reducing media (eg, thioglycolate broth) remove oxygen and are used to culture anaerobic organisms.
A synthetic medium is any chemically-defined medium for which all of the chemical contents are known
Biotin

Female Histology

Bone mets

Thoracic Outlet

This patient's presentation suggests thoracic outlet syndrome (TOS). The thoracic outlet is the space above the first rib and behind the clavicle that is bordered by the cervical vertebral bones and the sternum. Compression of the lower trunk of the brachial plexus as it passes through the thoracic outlet causes TOS and presents with upper extremity numbness, tingling, and weakness. In addition, compression of the subclavian vein can cause upper extremity swelling, whereas compression of the subclavian artery can cause exertional arm pain.
TOS most commonly occurs within the scalene triangle, which is formed by the anterior and middle scalene muscles and the first rib. The anterior scalene muscle originates from the C3-C6 transverse processes and attaches to the scalene tubercle of the first rib. The middle scalene originates from the C2-C7 transverse processes and inserts into the posterior first rib. The brachial plexus trunks and subclavian artery pass between the anterior and middle scalenes; the subclavian vein runs anteromedial to the triangle. TOS can be due to an anomalous cervical rib, scalene muscular anomalies, or injury (eg, repetitive overhead arm movements, trauma).
Hypercalcemia

06/06/2017
Mesothelioma
Histopathology will show tumor cells with numerous, long slender microvilli and abundanttonofilaments. Immunohistochemical markers (eg, pancytokeratin) are useful in diagnosis.
Cells of adenocarcinoma, which can show glandular or papillary elements, have short and plump microvilli that distinguish adenocarcinoma from mesothelioma.
Atherosclerosis
After the abdominal aorta, the next most heavily involved vessels are (in decreasing order): the coronary arteries, the popliteal arteries, the internal carotids, and the circle of Willis.
Mucociliary Clearance

Mucociliary clearance is responsible for removing the vast majority of inhaled particles that lodge within the bronchial tree. Ciliated mucosal epithelium lines the pulmonary airways from the trachea to the proximal portions of the respiratory bronchioles. Mucus and fluid secreted onto this epithelial surface act to trap particles suspended in the inspired air. The trapped particles are constantly swept upward from the bronchioles toward the pharynx by cilia that collectively beat in the direction of the pharynx. The mucus and debris are then swallowed or expectorated upon reaching the pharynx.
The terminal bronchioles are covered by ciliated cuboidal epithelium and club cells, which help with mucociliary clearance in this region.
06/07/2017
Poison
Arsenic's first-line chelating agent is dimercaprol (eg, British Anti-Lewisite), which increases urinary excretion of heavy metals by forming stable, nontoxic soluble chelates.
Acute lead poisoning can present with constipation, anemia, and irritability and confusion. CaNa2EDTA is a treatment option for lead toxicity and works by forming non-ionizing salts to increase urinary lead excretion.
Deferoxamine is the preferred chelating agent for iron overdoses or overload due to multiple blood transfusions. It binds circulating iron and facilitates its urinary excretion.
Cyanide poisoning presents with confusion, flushing or a "cherry-red" skin color, abdominal pain, and vomiting. Its antidote, hydroxycobalamin (vitamin B12 precursor), binds to intracellular cyanide forming cyanocobalamin, which can be easily excreted in urine.
Methylene blue is indicated for treatment of methemoglobinemia, which presents with gray- or blue-colored skin, shortness of breath, and "chocolate-colored" blood. Methylene blue acts as an artificial electron transporter for reduction of methemoglobin through the NADPH pathway.
Hep B
This results in the appearance of a finely granular, diffusely homogeneous, pale eosinophilic cytoplasm ("ground-glass" hepatocytes).
Xanthalesma
The lesion pictured is a xanthelasma, a type of xanthoma usually found on the medial eyelids. Hyperlipidemia and/or dyslipidemia can result in xanthomas (including xanthelasmas). Xanthelasmas are dermal accumulations of benign-appearing macrophages with abundant, finely vacuolated (foamy) cytoplasm containing cholesterol (free and esterified), phospholipids, and triglycerides.
Antihyperlipidemias
Last updated